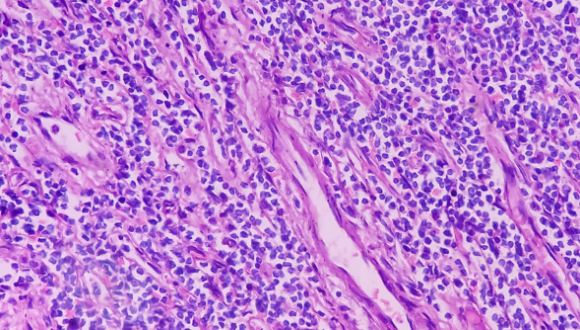
Developmental Maturation of Olfactory Circuits Underlying Innate Behavior Developmental Maturation of Olfactory Circuits Underlying Innate Behavior

Developmental Maturation of Olfactory Circuits Underlying Innate Behavior
Physiology and Pharmacology Dept.
You are cordially invited to a special seminar
of the Department of Physiology and Pharmacology
By:
Elham Taha, PhD
Developmental Maturation of Olfactory Circuits Underlying Innate Behavior
How sensory circuits mature to generate reliable behaviors, and how innate and learned attributes of brain function emerge during development, remain largely open questions. My postdoctoral work addressed these questions through the olfactory system, focusing on innate approach and avoidance behaviors. I will present findings showing that mitral cell projections from the olfactory bulb to the cortical amygdala (CoA), a key hub for innate odor valence, are still structurally and functionally immature in juvenile mice. Using viral tracing, two-photon calcium imaging, and behavioral assays, I demonstrated that juveniles exhibit weak odor representations that fail to trigger innate responses, whereas adults show refined, high-fidelity CoA-projecting ensembles that drive innate behavior. Optogenetic activation of CoA-projecting mitral cell terminals in juveniles was sufficient to rescue these behaviors, revealing a developmental bottleneck located upstream of the CoA.
I will also present my future research plan to define how olfactory circuits mature and adapt to shape more complex social behavior. Using systems neuroscience approaches, I plan to examine how olfactory circuits engage with downstream social circuits, particularly how olfactory– amygdalar circuits develop in the context of social behaviors like aggression, avoidance, and affiliation. Together, my work focuses on revealing core principles by which sensory circuits develop and adapt to generate flexible social behaviors.
The Seminar will take place on Tuesday, December 30th, 10:15-11:00
At the Faculty of Medical & Health Sciences, Room 100